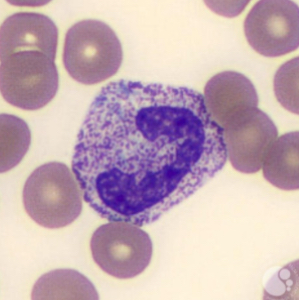
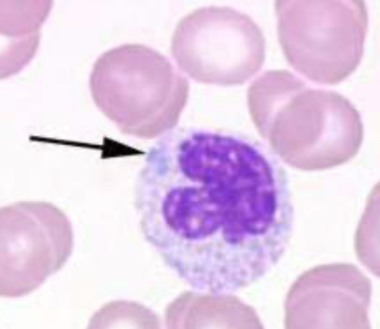
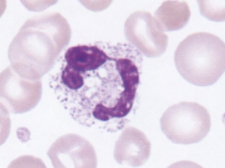
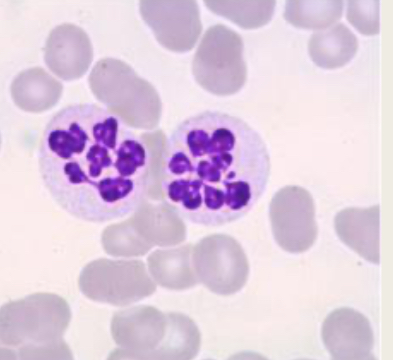
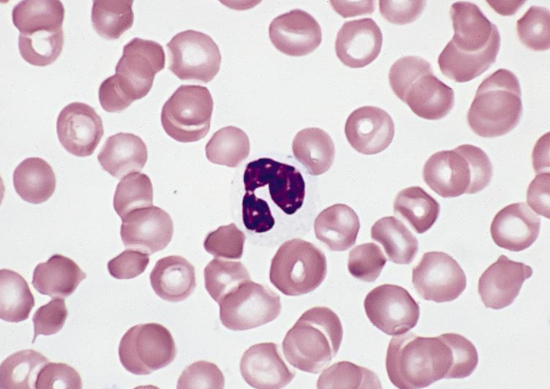
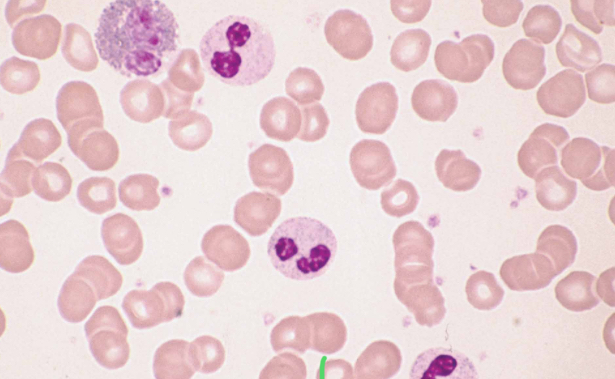
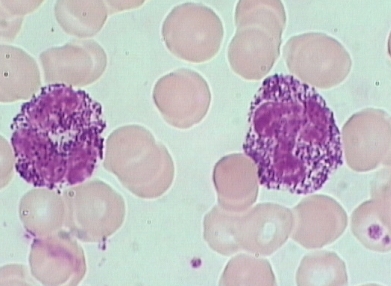
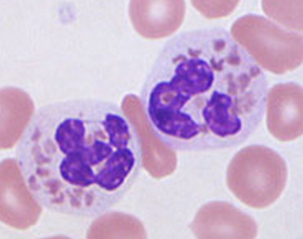
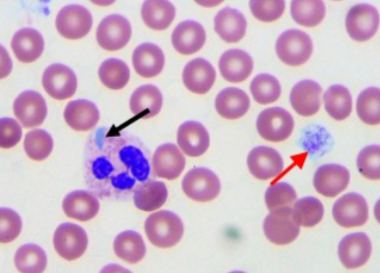

WBC anomolies (photos)
0.0(0)
Card Sorting
1/10
There's no tags or description
Looks like no tags are added yet.
Study Analytics
Name | Mastery | Learn | Test | Matching | Spaced |
|---|
No study sessions yet.
11 Terms
1
New cards
Toxic granulation
2
New cards
Dohle Bodies
3
New cards
Vacuolization/cytoplasmic vacuoles
4
New cards
Hypersegmentation
5
New cards
Auer Rods

6
New cards
Hypogranulation
7
New cards
Pelger-huet Anomaly
8
New cards
Alder-Reilly Anomly
9
New cards
Chediak-Higashi Syndrome
10
New cards
May-Hegglin
11
New cards